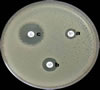

| Kolistin |

Kolistin |
| Bakteri izolasyon antibiyotiği.Genellikle anaerobik bakterilerin selektif izolasyon ve ön identifikasyonunda kullanılan bir antibiyotik. |
| Kolistin |
Kolistin |
| Bakteri izolasyon antibiyotiği.Genellikle anaerobik bakterilerin selektif izolasyon ve ön identifikasyonunda kullanılan bir antibiyotik. |